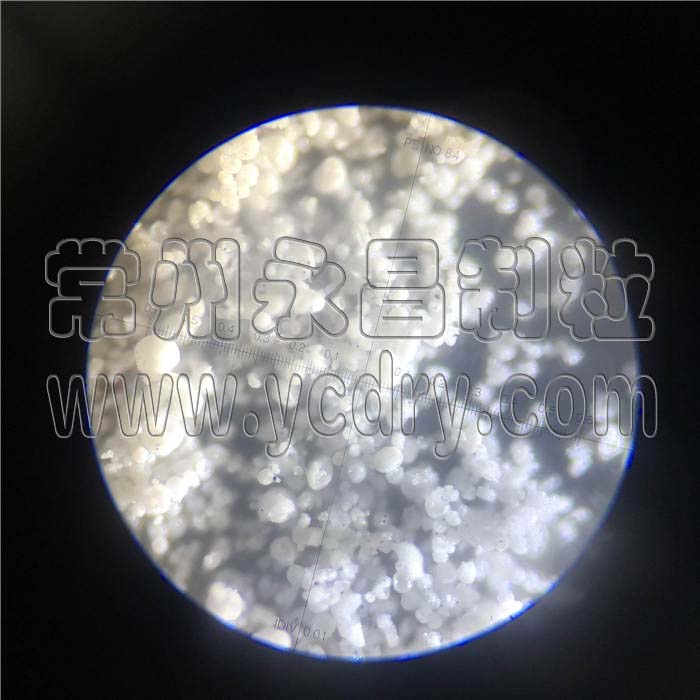

Calcium acetate spray dryer Beijing pharmaceutical industry with material trial
Free samples for the prototype
Spray dryer is a kind of special drying equipment for emulsion, suspension, paste, solution and other liquid drying. In polymers and resins: dyes, pigments: ceramics, glass, rust removers, pesticides: carbohydrates, dairy products: detergents and surfactants; Fertilizer: organic compounds, inorganic compounds on the drying of the family, particularly well.
Its drying speed is fast, generally only 5-15 seconds, with instantaneous drying characteristics; The drying process of materials is completed within a short period of time, which is suitable for the drying of heat-sensitive materials and can keep the color, smell and taste of materials. The finished products are of high purity and good quality. The production process is simplified. Easy operation and control, suitable for continuous control of production: wet content of 40% to 90% of the liquid, a drying into powder, reduce crushing, screening and other processes; Product dispersion, fluidity, good solubility, product particle size, loose density, water content can be adjusted in a certain range.